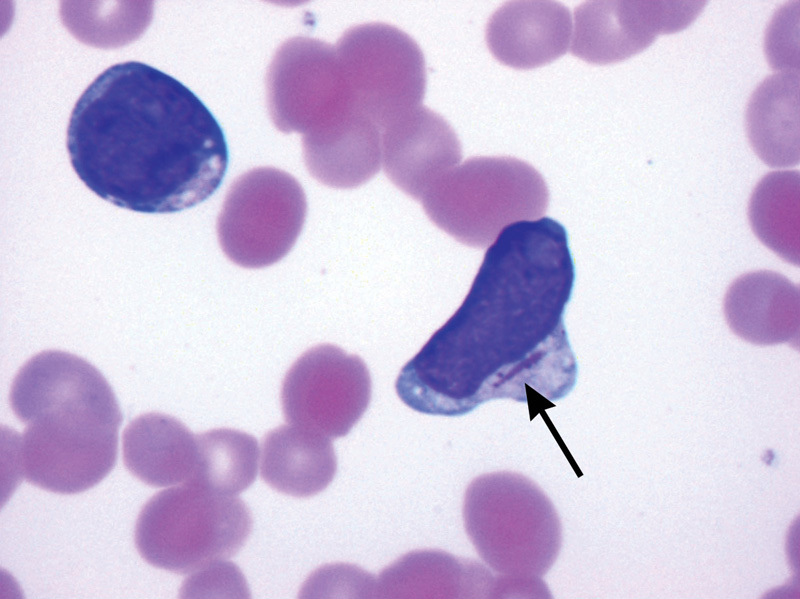

Pt presents with prog fatigue / easy brusing / dyspnea / hypoxia / worsening mental status –> WBC > 100k
Has the following cells on smear, below:
Dx? Dx is assoc with what t(x, x) situation?
Name of image on smear?
Tx
Dont forget a HIGH concern for ___ in pts with this condtion!

Dx
assoc with t(15,17)
Name of image on smear –> Auer Rods
Tx?
HIGH concern for *DIC* in pts with this AML
Elderly patient presents with fatigue, easy bruisability, and cervical lymphadenopathy -> CBC with 60K WBC and 95% lymphocytes and this smear (see attachment 2)
Dx?
Order what DxM?
Associated with?

Young patient presents with painless lymphadenopathy, fever, night sweats, weight loss, and pruritis:
Dx?
DxM?
If it is positive, they need what?
Tx? (and prognosis is based on ___)
Lymphoma
-> order excisional LN biopsy -> if positive needs CT CAP
Tx
-> multidrug chemo is treatment
(prognosis based on stage – see below). We had to know staging last year (ridiculous, I know!)
Lymphoma staging:
Stage I 1 node or group
Stage II 2 or more lymph node groups, same side of the diaphragm
Stage III Spans the diaphragm
Stage IV Disseminated disease
Subscripts for lymphoma staging
A B symptoms absent
B B symptoms present
X Bulky disease –defined as any mass >10 cms or a mass > 1/3 the diameter of the chest
E Extranodal disease
Dx?
What do you see?
t(x, x)?
AML
Auer Rods
t(15,17)
Dx?
Assoc with?

CLL
Assoc with hemolytic anemia and ITP
symptomatic hyperleukocytosis
Tx with eukapheresis and start ATRA prior to chemo
This is treatment for what oncology dz?
AML
associations with some onc dz:
DIC?
hemolytic anemia and ITP?
DIC: high concern in AML pts
hemolytic anemia: in CLL pts
Lymphoma staging:
One node or group
Stage I
Lymphoma staging:
2 or more lymph node groups, same side of diaphragm
Stage II
Lymphoma staging:
Spans the diaphragm
Stage III
Lymphoma staging:
Disseminated dz
Stage IV
Subscripts for lymphoma staging:
If B symptoms are absent –> A
If B symptoms are present –> B
Bulky disease (defined as any mass >10 cms or a mass > 1/3 the diameter of the chest) –> X
Extranodal disease –> E